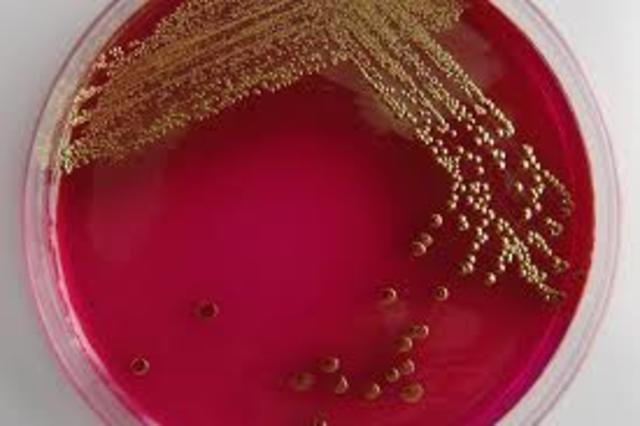
robert koch descubre colonias bacterianas

-
En europa aumentan cultivos de leguminosas y practican la rotacion de cultivos para el redimiento y uso de la tierra
-
-
-
las herramientas agricolas se vuelven populares en europa y ee.uu. se introduce alimentopara animales procesado industrialmente y fertilizantes inorganicos ,revolucionando las practicas agricolas
-
sus experimentos posteriores demostraran que la fermantacion es el resultado de la actividad de levaduras y bacterias
-
-
-
-
-
(enzima que convierte al disacarido sacarosa en glucosa y fructosa) usada en la actualidad para producir endulzantes.
-
-
-
-
patogenos bacterianos responsables del colera aviario y del antrax y con esto se abre campo a la medicina preventiva.
-
-
-
-
-
Plan projects on a visual timeline
Map milestones, phases, deadlines, and key events in one place so the sequence is easier to see and share. Timetoast is a timeline maker for work, school, research, and stories.